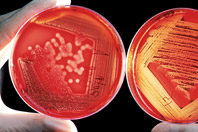

«Форсига» продемонстрировала значимое снижение риска госпитализации по причине сердечной недостаточности и / или сердечно-сосудистой смерти в широкой популяции пациентов с сахарным диабетом 2 типа в исследовании DECLARE-TIMI 58
В группе пациентов, получавших терапию препаратом «Форсига», также наблюдалась меньшая частота развития крупных сердечно-сосудистых событий по сравнению с плацебо, однако разница не достигла статистической значимости. В исследовании не было увеличения рисков в отношении ампутаций, переломов, рака мочевого пузыря или гангрены Фурнье у пациентов, принимавших препарат «Форсига», по сравнению с плацебо. По вторичным конечным точкам «Форсига»…